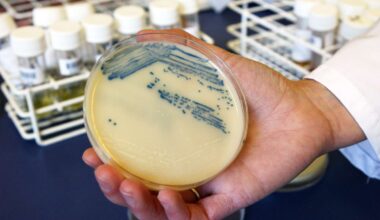
Deadly Drug-Resistant Fungus Is Sweeping Through Hospitals

‘Comfort break’: UK doctor abandons patient mid-surgery to have sexual activity with nurse; now works in Pakistan | World News
A 44-year-old consultant anaesthetist left a patient under anaesthesia during surgery to engage in sexual activity with a…